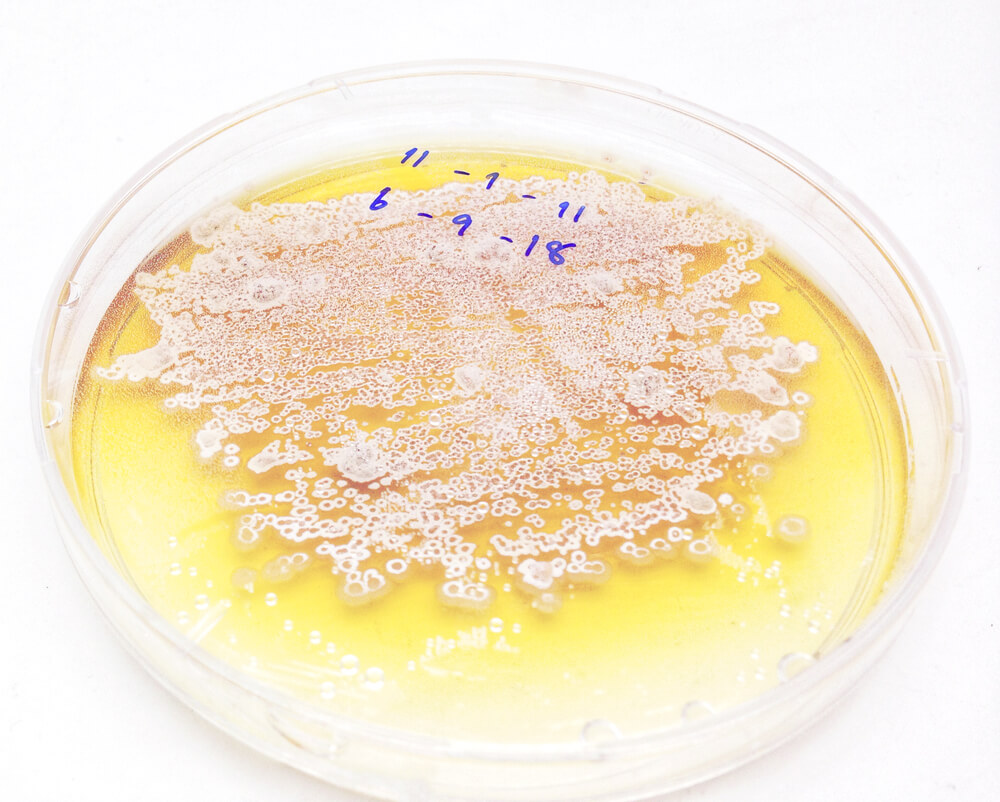

¿Por qué se producen las anginas?

La amigdalitis es la inflamación de las amígdalas, a la que nos referimos comúnmente denominándola “anginas”. Es una afección usualmente leve que prácticamente todos nosotros hemos padecido en alguna ocasión. Consiste en una irritación de las vías respiratorias altas.
Aunque puede aparecer en cualquier época del año, la incidencia aumenta ampliamente en invierno, junto con los procesos catarrales y gripales. A continuación veremos las causas que producen las anginas.
¿Por qué se inflaman las amígdalas?
Las amígdalas se localizan en la faringe y tienen una función de defensa de nuestro organismo frente a agentes externos. Estos agentes externos pueden ser bacterias o virus. Por esta razón, se inflaman cuando atravesamos un proceso infeccioso, síntoma de que nuestro cuerpo está reaccionando contra el patógeno.
Las anginas son más frecuentes durante la infancia porque, en esta época, es cuando se produce por primera vez el contacto con los distintos gérmenes. Nuestro sistema inmune va madurando poco a poco con ellos.

¿Cuáles son las causas que producen las anginas?
La causa más común por la que se producen las anginas es la infección causada por bacterias o virus; pero también puede ser por causas de naturaleza alérgica, química, secundaria a otras enfermedades o, incluso, traumática. En cualquier caso, padecer anginas es un síntoma inespecífico de la lucha de nuestro organismo contra un germen o agente externo.
A continuación, desarrollamos las causas más frecuentes de las anginas:
Anginas causadas por una infección viral
Los virus son responsables de más del 50 % de amigdalitis, tanto en población infantil como adulta. Los agentes causales más frecuentes son los virus Influenzae, Parainfluenzae, Herpes, Coxsackie y Adenovirus. Todos ellos pueden dar lugar a una inflamación de las anginas por sí mismos o predisponer a una infección bacteriana.
Los síntomas que acompañan a las anginas producidas por virus son:
- Febrícula (fiebre ligera).
- Tos.
- Congestión nasal.
- Enrojecimiento difuso de la orofaringe.
- Adenopatías difusas.
En este caso, el tratamiento de las anginas suele ser sintomático.
Anginas por infecciones bacterianas
Es otra de las causas más frecuentes. Aproximadamente el 40 % de las amigdalitis se deben a microorganismos bacterianos, especialmente por los estreptococos, siendo el mayor causante el estreptococo beta-hemolítico del grupo A. Otras familias de bacterias que pueden producir anginas son Pneumococo, Staphylococo, Haemophylus influenzae y Corinebacterium.
Cuando la inflamación de las anginas es producida por una infección bacteriana, normalmente aparece de forma brusca, acompañada de fiebre alta, dolor intenso y adenopatías cervicales. Estas infecciones pueden provenir de un desequilibrio de nuestra propia flora bacteriana o pueden ser debidas a otros virus y/o bacterias externos.
Quizá te interese: Azitromicina
¿Qué podemos hacer para prevenir las anginas o minimizar sus complicaciones?
Algunas recomendaciones para prevenir la amigdalitis son:
- Lavarse las manos de manera frecuente.
- Utilizar pañuelos de papel de un único uso.
- Evitar cambios bruscos de temperatura.
En el caso de que lo que quieras sea minimizar las complicaciones, puedes tener en cuenta los siguientes consejos:
- Aumentar la ingesta de líquidos.
- Dieta ligera.
- No forzar la voz.
- Evitar fumar.
Leer también: ¿Cuándo tomar suplementos vitamínicos?
En conclusión, las anginas se producen fundamentalmente por una infección vírica o bacteriana. Normalmente, suelen resolverse con tratamiento sintomático o antibióticos, sin complicaciones. Los niños son especialmente vulnerables a esta afección.
- ChacónMartínez J, Puebla Morales JM, Padilla Parrado M. Patología inflamatoria inespecífica de la faringe. Libr virtual Form en ORL. 2014:1-15.
- Font E. Faringitis y amigdalitis . Tratamiento etiológico y sintomático. Ambito Farm. 2001:71-76.
- Barreras JI. Fisiología del anillo de Waldeyern. Faso. 2014;2(2):79-81. http://www.faso.org.ar/revistas/2014/2/13.pdf.
- Stelter K. Tonsillitis and sore throat in childhood. Laryngorhinootologie. 2014;93 Suppl 1:84-102. doi:10.1055/s-0033-1363210
- Franz Baehr M, Jorge Mackenney P. Aspectos clínicos de la influenza. Rev Médica Clínica Las Condes. 2014;25(3):406-411. doi:10.1016/S0716-8640(14)70056-2
Este texto se ofrece únicamente con propósitos informativos y no reemplaza la consulta con un profesional. Ante dudas, consulta a tu especialista.